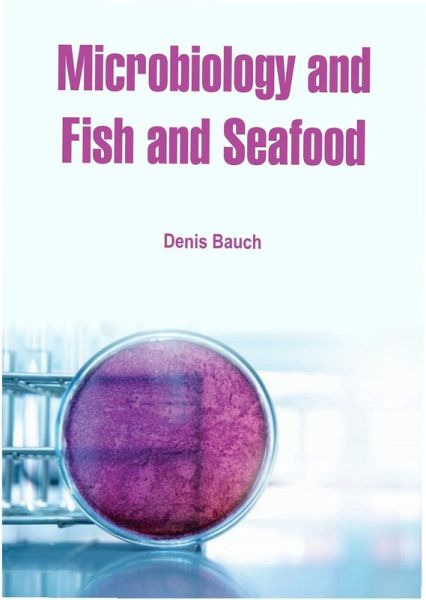

Microbiology and Fish and Seafood (eBook, ePUB)

PAYBACK Punkte
141 °P sammeln!
Microbiology and Fish and Seafood - Fish and Seafood is one in a series of MedTech's Food Sciences Handbooks; others include Dairy Products, and Meat Products. This book endeavours to provide the reader with an easy-to-use reference to microorganisms in fish and seafood.This handbook remains topical and features recent development in fish and seafood processing that can influence the nature and scoope of growth and survival of microorganisms in these products, and hazards associated with them. The products include: Chilled and Frozen Raw Fish Chilled and Frozen Prepared Fish Molluscan Shellfis...
Microbiology and Fish and Seafood - Fish and Seafood is one in a series of MedTech's Food Sciences Handbooks; others include Dairy Products, and Meat Products. This book endeavours to provide the reader with an easy-to-use reference to microorganisms in fish and seafood.This handbook remains topical and features recent development in fish and seafood processing that can influence the nature and scoope of growth and survival of microorganisms in these products, and hazards associated with them. The products include: Chilled and Frozen Raw Fish Chilled and Frozen Prepared Fish Molluscan Shellfish Crustacean Shellfish Cured, Smoked and Dried Fish Fermented Fish Fish and Shellfish ToxinsThis book also incorporates the new Commissition Regulations on hygiene for foodstuffs and specific hygiene rules for food of animal origin, as well as microbiological criteria for foodstuffs; and new fish and shellfish toxins Lipophilic Shellfish Toxins, Azaspiracids, Cyclic Imines, Gymnodimines, Spirolides, Pinnatoxins and Pteriatoxins.This book remains a valuable source of information for microbiologists and food scientists responsible for food safety.
Dieser Download kann aus rechtlichen Gründen nur mit Rechnungsadresse in A, B, BG, CY, CZ, D, DK, EW, E, FIN, F, GR, HR, H, IRL, I, LT, L, LR, M, NL, PL, P, R, S, SLO, SK ausgeliefert werden.













